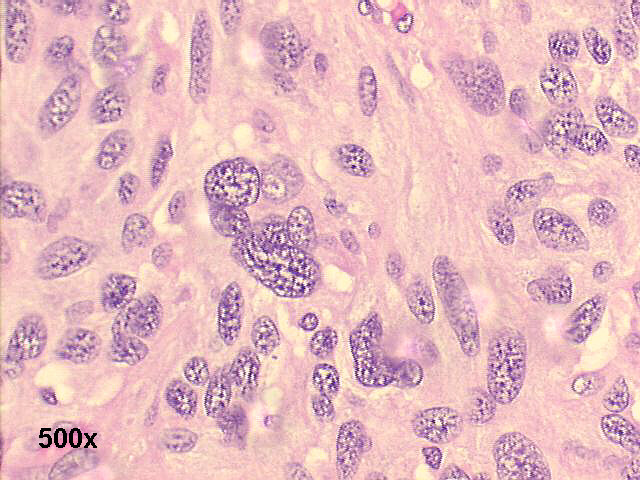
H&E histology ~ many fusiform, sarcomatous cells

|

The smears show several large spindle shaped cells, and some anaplastic ones. Our cytological diagnosis was high grade sarcoma, predominantly spindle shaped, probable MFH. Histopathology of the resected tumor confirmed the presence of a high grade sarcoma, with storiphorm/pleomorphic morphology. Histochemistry of the tumor revealed Vimentin positivity; Melanoma markers (S100, HMB45) negativity. Carcinoma markers (cytokeratin AE1/3, EMA, CK7, CK20), lymphoma markers (CD45, CD20, CD3, CD4, CD43, CD5, CD30) and markers for specific sarcomas (SMA, CD34, CD117, HHF35, and desmin) were all negative.We consider this, by exclusion, a case of malignant fibrous histiocytoma, with predominant spindle cell morphology, but with areas of high grade pleomorphic sarcoma. Two years later this patient developed local recurrence.
|